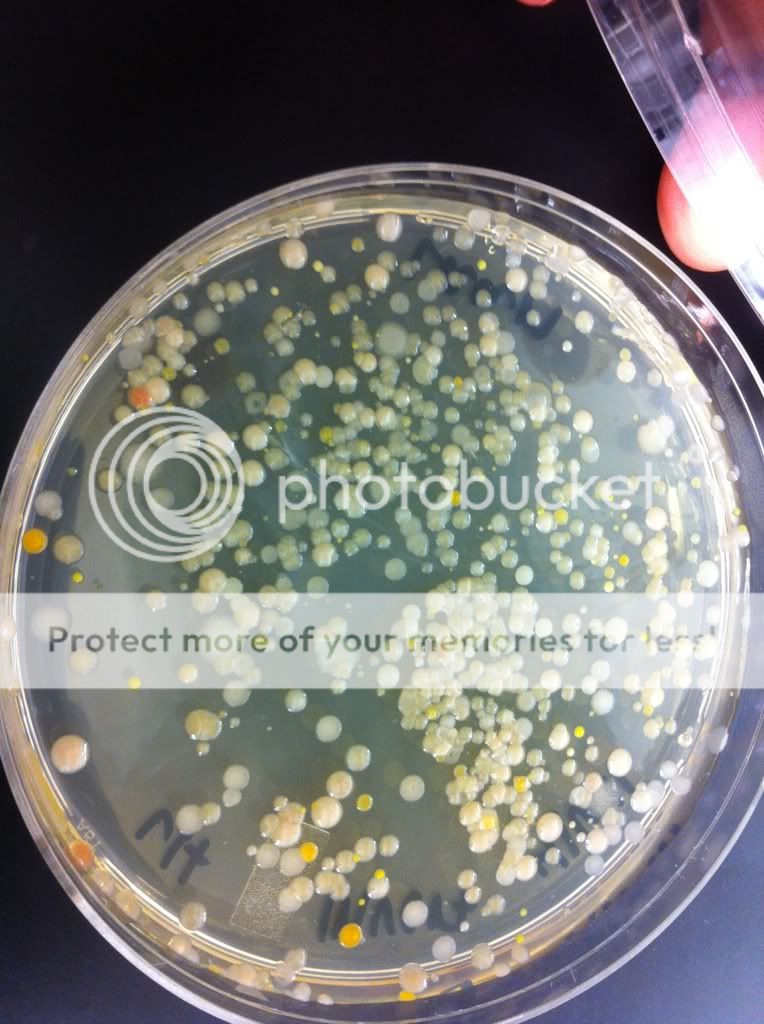
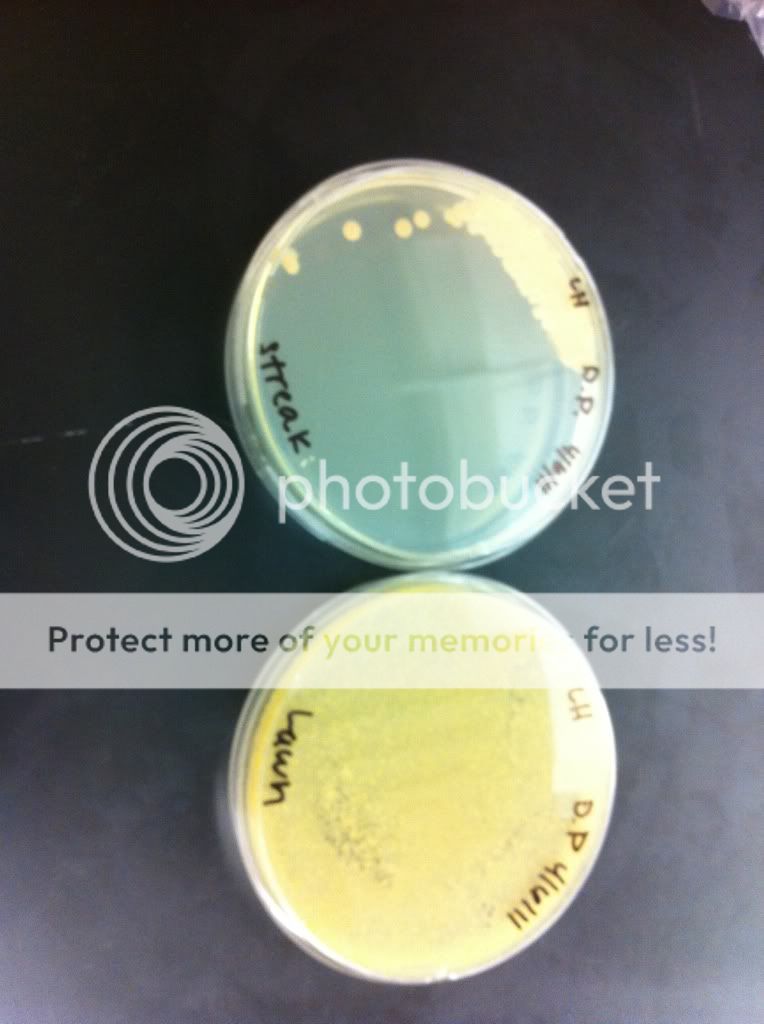
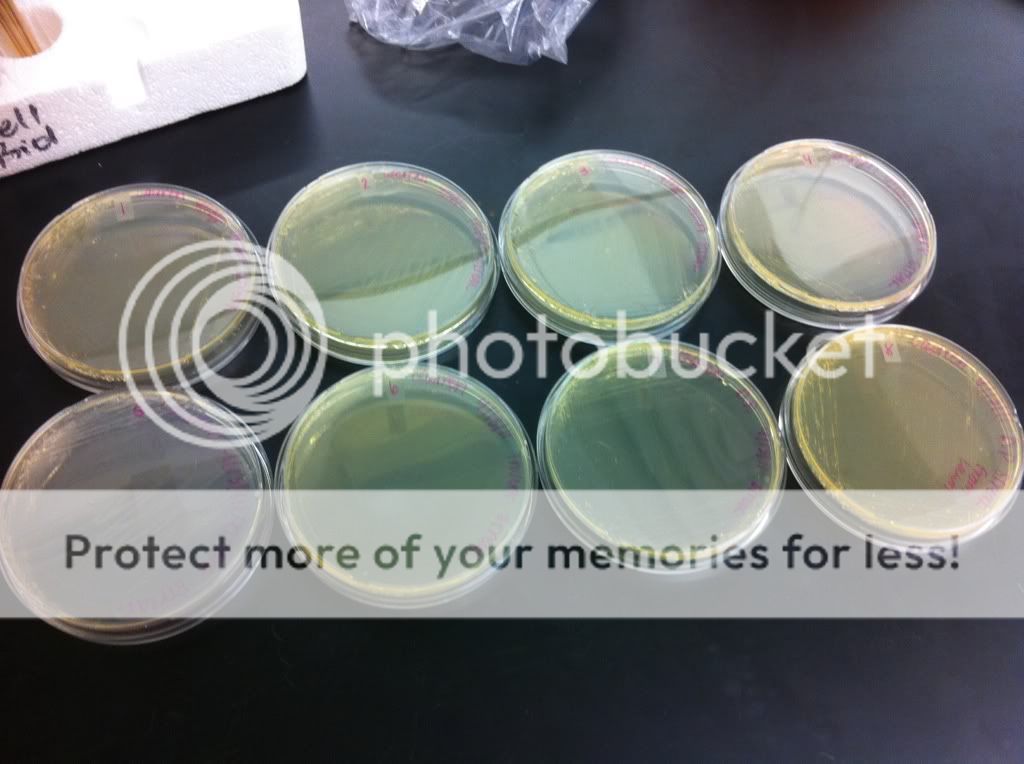

Here are the results after the initial round in the anerobic chamber
The streak plate and the lawn plate from the Dwarf Puffer tank

DP lawn

as you can see in this one there is one morphology of bacteria present and proliferate in the the lawn, the streak is lacking due to error on my part.
Here is the streak and the lawn from the invert tank.

Invert lawn

as you can see there are many more morphologies on this plate. 6 in total
1. Orange smooth colony
2.White smooth colony
3. Peach smooth colony
4. White rough colony
5. Small yellow smooth colony
6. Pink(ish) smooth colony
I made a plate of each of these colonies to further isolate them.

There is 8 in this picture because I did a streak of the DP slides for consistency
After talking to my professor he explained that the anaerobic chamber was to select for bacteria that are anaerobic and select against anything else in the water that needs oxygen to survive and could be considered a contaminant.
The streak plate and the lawn plate from the Dwarf Puffer tank

DP lawn

as you can see in this one there is one morphology of bacteria present and proliferate in the the lawn, the streak is lacking due to error on my part.
Here is the streak and the lawn from the invert tank.

Invert lawn

as you can see there are many more morphologies on this plate. 6 in total
1. Orange smooth colony
2.White smooth colony
3. Peach smooth colony
4. White rough colony
5. Small yellow smooth colony
6. Pink(ish) smooth colony
I made a plate of each of these colonies to further isolate them.
There is 8 in this picture because I did a streak of the DP slides for consistency
After talking to my professor he explained that the anaerobic chamber was to select for bacteria that are anaerobic and select against anything else in the water that needs oxygen to survive and could be considered a contaminant.


